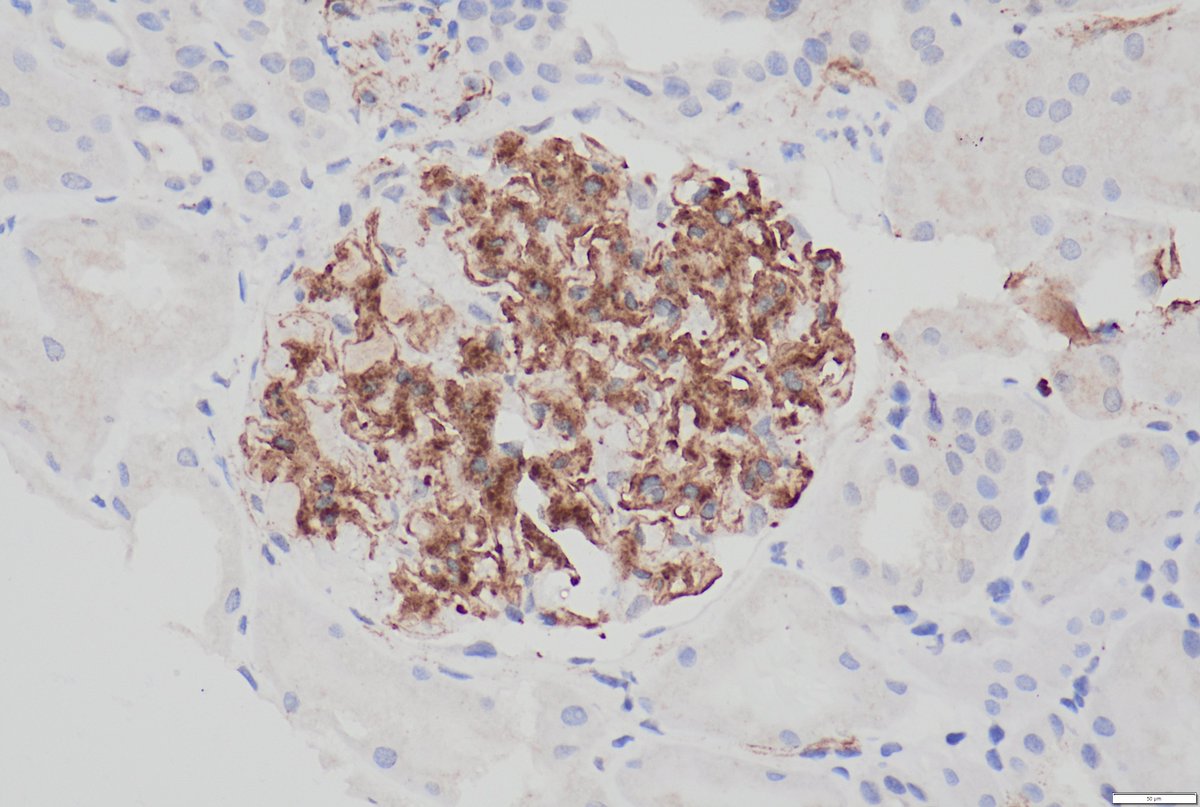

Pallav Gupta Renal Pathologist@SGRH
@pallavkmc1
Interests Renal Path tx infection wrote"Pathology of Glomerular dis."
Pathology of opportunistic infection Atlas Springer
Dream Plan Execute
❤ to make friends
ID: 140876903
06-05-2010 15:55:36
172 Tweet
191 Takipçi
69 Takip Edilen









Lupus nephritis (native) : classic immune thrombi, wire loop lesions & endocapillary cells++. Extra glomerular immune deposits : C1q( PTC/TBM staining). EM: “wire-loop” & PTC immune deposits. Read our 📝 on lupus in TX. Mayo Clinic Pathology Mayo Clinic Nephrology Mayo Clinic Transplant KIReports